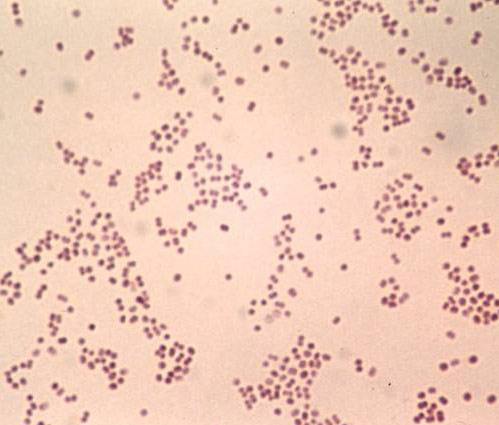

Другие названия и синонимы
N74.3 Female gonococcal pelvic inflammatory disease (A54.2+), N74.3.
Описание
Нет подробного описания, смотрите связи
|
|
|
|
N74.3 Гонококковые воспалительные болезни женских тазовых органов (A54.2+) |
|
|